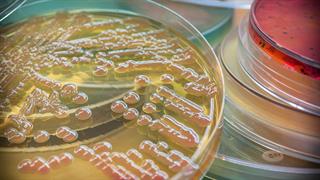

Δευτέρα, 05 Μαΐου 2025, 09:42
ΕΟΔΥ: Γάντια και υγιεινή χεριών κατά των ενδονοσοκομειακών λοιμώξεωνΤι επισημαίνουν οι ειδικοί του Οργανισμού με αφορμή τη σημερινή Παγκόσμια Ημέρα της Υγιεινής Χεριών.
Τρίτη, 15 Οκτωβρίου 2024, 16:56
ΠΟΕΔΗΝ: Διπλάσιες οι ενδονοσοκομειακές λοιμώξεις στην Ελλάδα σε σχέση με την ΕυρώπηΤι αναφέρει ο Μιχάλης Γιαννάκος με αφορμή τα αποτελέσματα από την εφαρμογή σχετικού προγράμματος.
Τρίτη, 03 Σεπτεμβρίου 2024, 08:00
Candida Auris: Ευρεία εξάπλωση, αντιμετωπίσιμη επί του παρόντοςΤι προκύπτει από τη μελέτη του Εργαστηρίου Μικροβιολογίας του ΑΠΘ στα νοσοκομεία της Β.Ελλάδας. Μιλάει στο iatronet.gr ο διευθυντής του Εργαστηρίου καθηγητής Τ. Βυζαντιάδης.
Τετάρτη, 08 Μαΐου 2024, 12:20
ECDC: Με ενδονοσοκομειακή λοίμωξη 1 στους 8 Έλληνες ασθενείς - Διπλάσιοι από τους Ευρωπαίους [πίνακες]Πώς επηρέασε την εικόνα ο κορωνοϊός. Τι επισημαίνεται σε έκθεση του Ευρωπαϊκού Κέντρου Ελέγχου Νοσημάτων.
Παρασκευή, 08 Μαρτίου 2024, 14:31
Η Β. Βιλδιρίδη πρόεδρος επιτροπής για τη μείωση των ενδονοσοκομειακών λοιμώξεωνΔιπλάσιο είναι το πρόβλημα στην Ελλάδα σε σχέση με την Ευρώπη, όπως προκύπτει από πρόσφατη μελέτη του ΕΟΔΥ.
Δευτέρα, 19 Φεβρουαρίου 2024, 12:15
Κρεσομυκίνη: Nέο αποτελεσματικό αντιβιοτικό κατά των πολυανθεκτικών βακτηρίωνΕλπιδοφόρα αποτελέσματα από in vitro δοκιμές. Εκκρεμούν οι κλινικές μελέτες.
Τετάρτη, 14 Φεβρουαρίου 2024, 17:49
ECDC: Υπερμολυσματικό στέλεχος Klebsiella pneumoniae σε 10 ευρωπαϊκές χώρεςΠρόκειται για βακτήριο, το οποίο προκαλεί σοβαρές λοιμώξεις, κυρίως σε ενδονοσοκομειακό περιβάλλον.
Τετάρτη, 06 Δεκεμβρίου 2023, 18:25
Πρωτιά της Ελλάδας στην κατάχρηση αντιβιοτικών, στη μικροβιακή αντοχή και στους θανάτους από ενδονοσοκομειακές λοιμώξειςΈνας στους τέσσερις Έλληνες φυλάει κάποιο αντιβιοτικό στο σπίτι για ώρα ανάγκης! -'Ερευνα της KΑΠΑ Research.
Δευτέρα, 27 Νοεμβρίου 2023, 13:04
Γιατί επιμένουν οι ενδονοσοκομειακές λοιμώξεις στην ΕλλάδαΤι απαντούν οι ειδικοί στην ΕΡΤ.
Παρασκευή, 22 Σεπτεμβρίου 2023, 19:10
Κρούσμα candida auris σε γυναίκα στα Χανιά - Νοσηλεύεται σε απομόνωσηTέθηκε σε εφαρμογή και το σχετικό πρωτόκολλο.



![ECDC: Με ενδονοσοκομειακή λοίμωξη 1 στους 8 Έλληνες ασθενείς - Διπλάσιοι από τους Ευρωπαίους [πίνακες]](/media/articles/photos/thumb/124724-patient.jpg)

Χρόνια νεφρική νόσος: Τι πρέπει να γνωρίζουμε
Χρόνια νεφρική νόσος: Τι πρέπει να γνωρίζουμε Πώς θα προλάβουμε τον διαβήτη
Πώς θα προλάβουμε τον διαβήτη Αλκοόλ και αντικαταθλιπτικά: Γιατί δεν πρέπει να τα συνδυάζουμε
Αλκοόλ και αντικαταθλιπτικά: Γιατί δεν πρέπει να τα συνδυάζουμε Μικροβιακή αντοχή: Μία πανδημία σε αργή κίνηση που μπορούμε να αποτρέψουμε
Μικροβιακή αντοχή: Μία πανδημία σε αργή κίνηση που μπορούμε να αποτρέψουμε